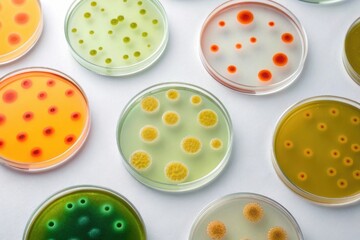
Fototapeta premium Multiple Petri Dishes with Colorful Bacterial Colonies in Laboratory

RABAT DO 40% - wygasa 12.03 !!! | Darmowa dostawa od 290zł | Potrzebujesz pomocy? Zadzwoń 22 678 07 67
(0)
Produkt dodany poprawnie do Twojego koszyka
Ilość
Razem
Ilość produktów w Twoim koszyku: 0. Jest 1 produkt w Twoim koszyku.
Razem produkty:
Dostawa: Do ustalenia
Razem
Kontynuuj zakupy Przejdź do realizacji zamówienia
Start > Fototapeta premium
Jakiego obrazu szukasz?
Użyj wyszukiwarki i szukaj wśród milionów zdjęć.
Fototapety Fototapeta premium
- #1102200960
- #454941469
- #1759186647
- #278649513
- #88800578
- #586818216
- #592458452
- #323378639
- #350888849
- #493817587
- #1914706358
- #940675518
- #1666567236
- #1177042058
- #1855171721
- #1058222221



![Fototapeta premium [Closeup of patterned cookies] Round food items with fruit-veg pattern on pink background soft focus baking cookies biscuits cutout close-up photography food styling prop](https://t3.ftcdn.net/jpg/11/54/74/16/240_F_1154741605_PRr8x8GACQkzoKCJS7S78YvkqFtxG3US.jpg)